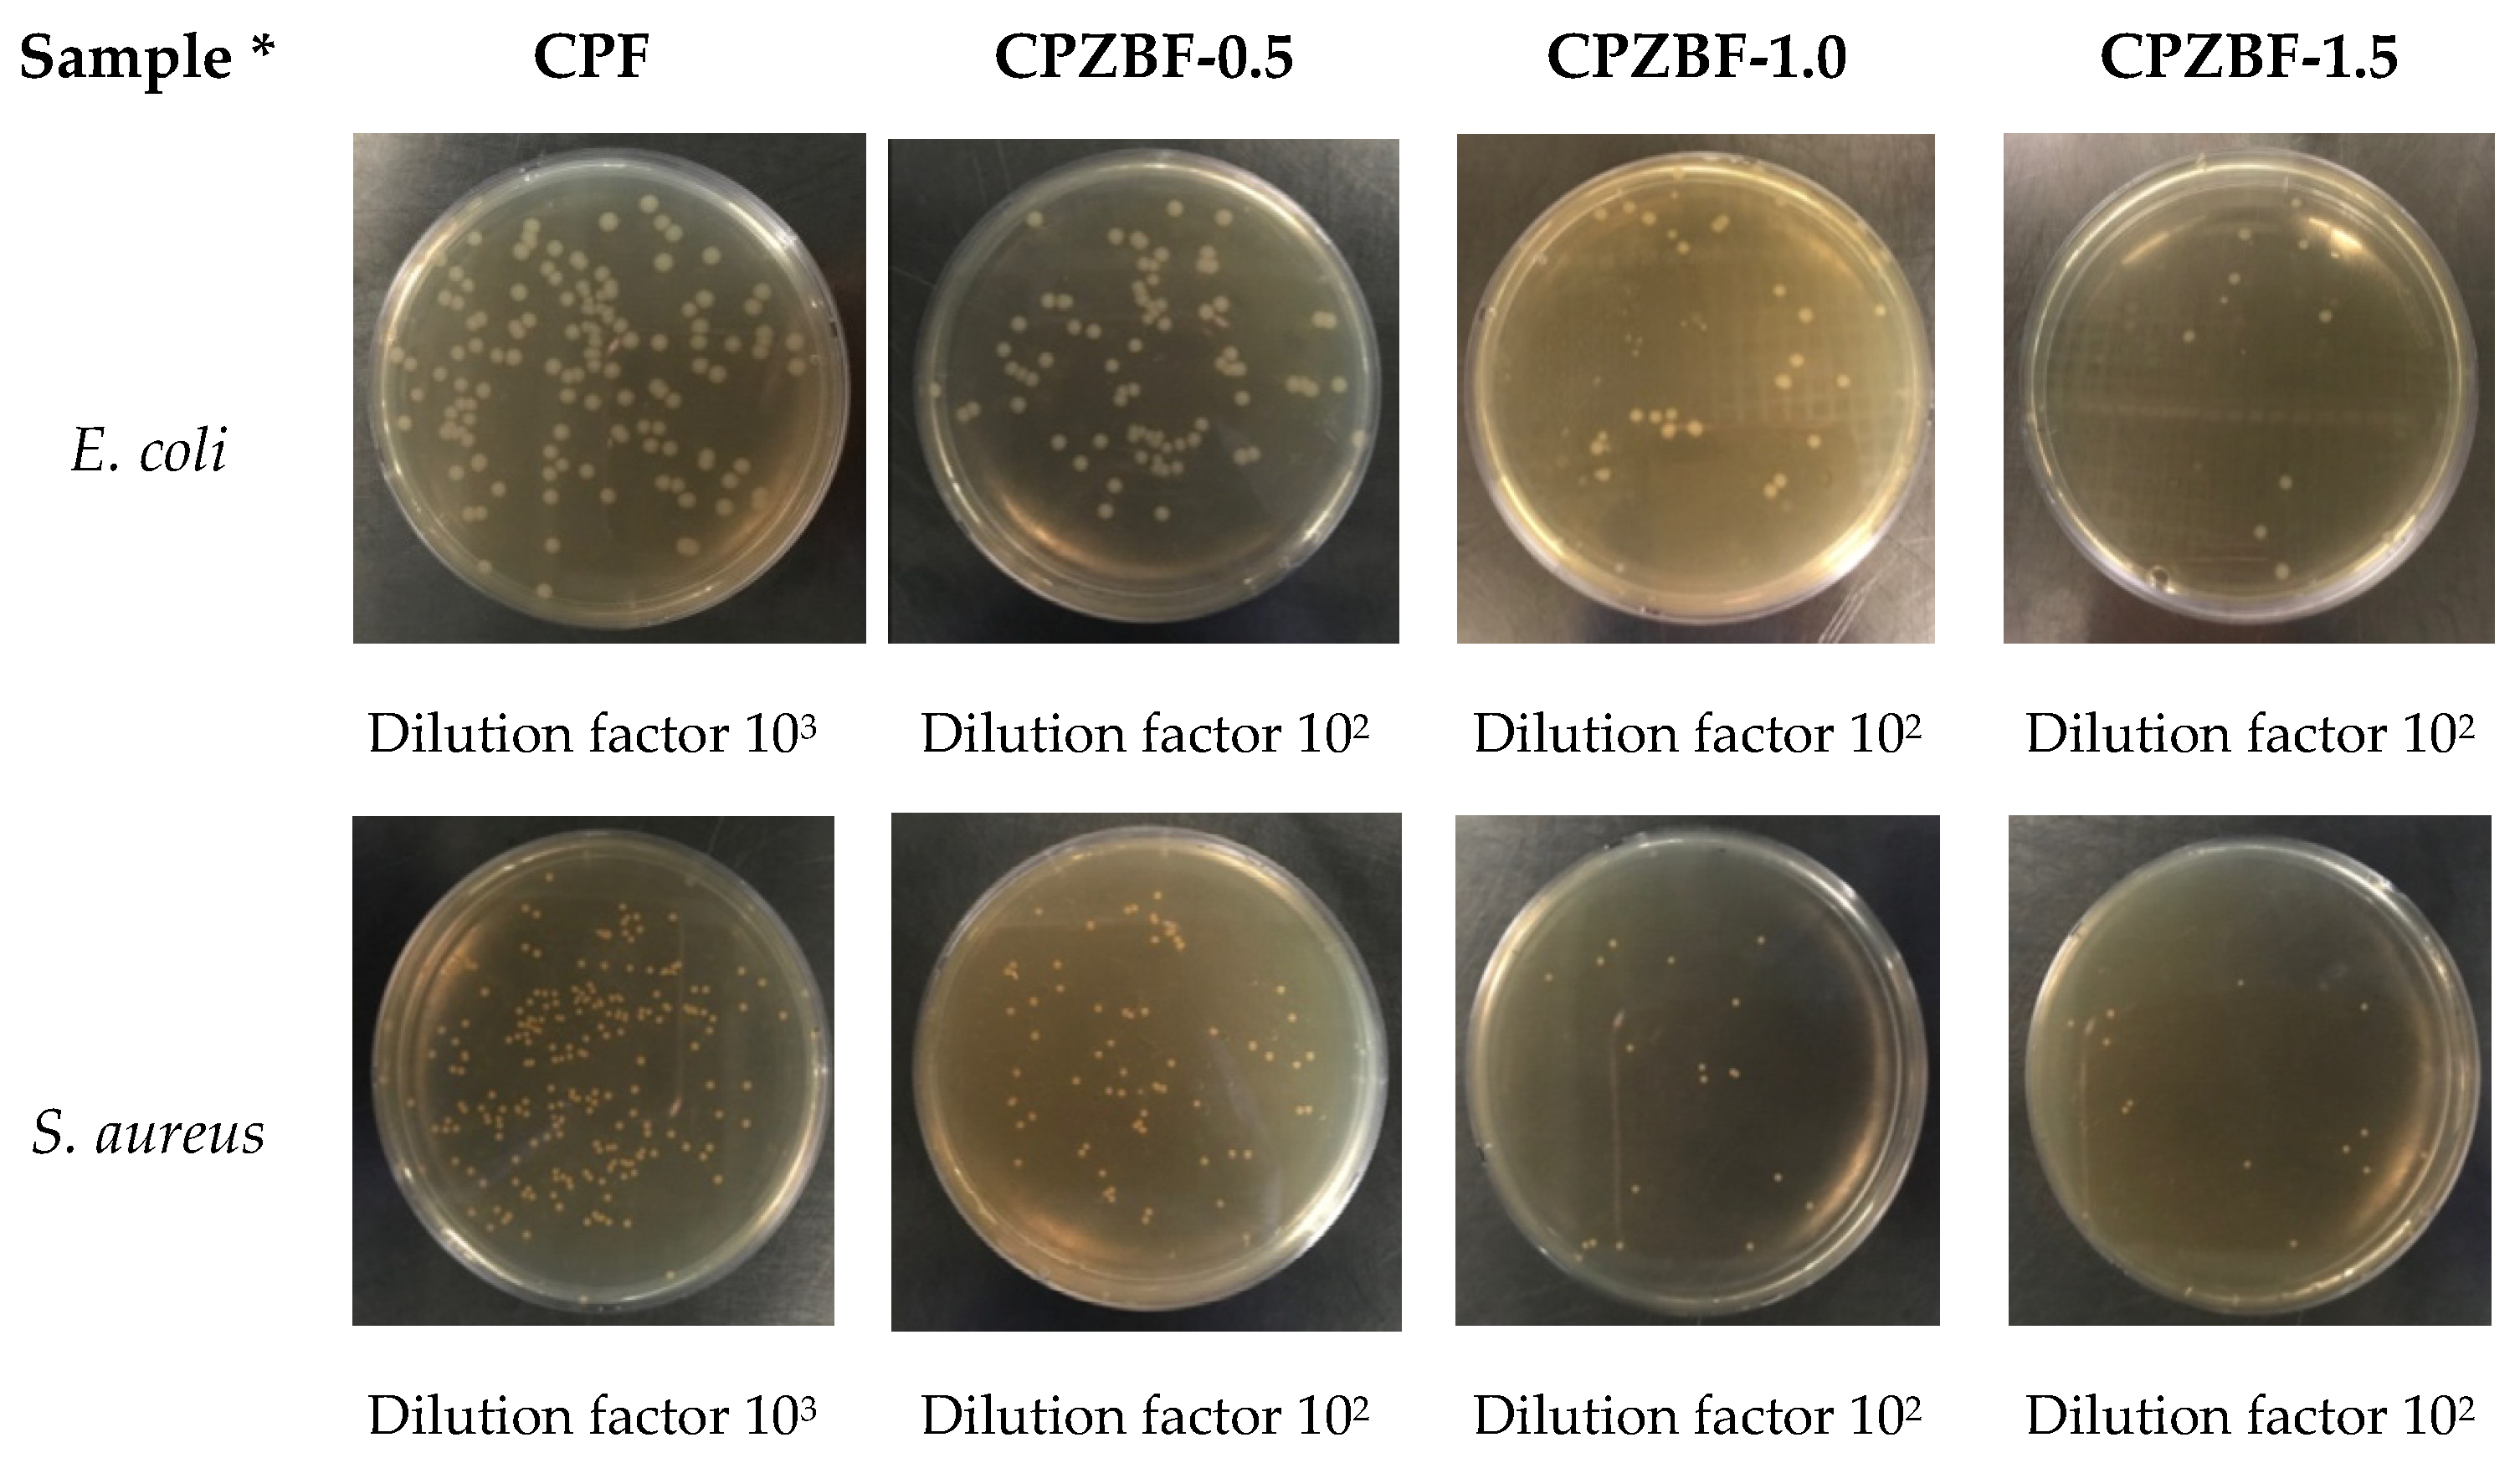
Polymers 13 02403 g005 550

Improvement of the UV Barrier and Antibacterial Properties of Crosslinked Pectin/Zinc Oxide Bionanocomposite Films
Abstract
:1. Introduction
2. Materials and Methods
2.1. Materials
2.2. Film Preparation
2.2.1. Crosslinked Pectin Films
2.2.2. Crosslinked Pectin/ZnO Bionanocomposite Films
2.3. Characterization of Bionanocomposite Films
2.3.1. Optical Properties
2.3.2. Mechanical Properties
2.3.3. Moisture Content
2.3.4. Water Solubility
2.3.5. Water Vapor Permeability (WVP)
2.3.6. FTIR Analysis
2.3.7. Differential Scanning Calorimetry (DCS)
2.3.8. Antibacterial Activity
2.4. Statistical Analysis
3. Results and Discussion
3.1. Characterization of Crosslinked Pectin Films
3.1.1. Mechanical Properties
3.1.2. Moisture Content and Water Solubility
3.1.3. FTIR Analysis
3.2. Characterization of Crosslinked Pectin/ZnO Bionanocomposite Films
3.2.1. Surface Color and Optical Properties
3.2.2. Mechanical Properties
3.2.3. Water Vapor Permeability (WVP)
3.2.4. DSC Analysis
3.2.5. Antibacterial Activity
4. Conclusions
Author Contributions
Funding
Data Availability Statement
Acknowledgments
Conflicts of Interest
References
- Jo, Y.; Garcia, C.V.; Ko, S.; Lee, W.; Shin, G.H.; Choi, J.C.; Park, S.J.; Kim, J.T. Characterization and antibacterial properties of nanosilver-applied polyethylene and polypropylene composite films for food packaging applications. Food Biosci. 2018, 23, 83–90. [Google Scholar] [CrossRef]
- Neira, L.M.; Agustinelli, S.P.; Ruseckaite, R.A.; Martucci, J.F. Shelf life extension of refrigerated breaded hake medallions packed into active edible fish gelatin films. Packag. Technol. Sci. 2019, 32, 1–10. [Google Scholar] [CrossRef]
- Duncan, T.V. Application of nanotechnology in food packaging and food safety: Barrier materials, antimicrobials and sensors. J. Colloid Interface Sci. 2011, 363, 1–24. [Google Scholar] [CrossRef] [PubMed]
- Rhim, J.W.; Park, H.M.; Ha, C.S. Bio-nanocomposites for food packaging applications. Prog. Polym. Sci. 2013, 38, 1629–1652. [Google Scholar] [CrossRef]
- Kim, J.T.; Netravali, A.N. Physical properties of biodegradable films of soy protein concentrate/gelling agent blends. Macromol. Mater. Eng. 2012, 297, 176–183. [Google Scholar] [CrossRef]
- Laurent, M.A.; Boulenguer, P. Stabilization mechanism of acid dairy drinks (ADD) induced by pectin. Food Hydrocoll. 2003, 17, 445–454. [Google Scholar] [CrossRef]
- Mellinas, C.; Ramos, M.; Jiménez, A.; Garrigós, M.C. Recent trends in the use of pectin from agro-waste residues as a natural-based biopolymer for food packaging applications. Materials 2020, 13, 673. [Google Scholar] [CrossRef] [Green Version]
- Aldana, D.S.; Andrade-Ochoa, S.; Aguilar, C.N.; Contreras-Esquivel, J.C.; Nevárez-Moorillón, G.V. Antibacterial activity of pectic-based edible films incorporated with Mexican lime essential oil. Food Control 2015, 50, 907–912. [Google Scholar] [CrossRef]
- Suyatma, N.E.; Ishikawa, Y.; Kitazawa, H. Nanoreinforcement of pectin film to enhance its functional packaging properties by incorporating ZnO nanoparticles. Adv. Mat. Res. 2014, 845, 451–456. [Google Scholar] [CrossRef]
- Chaichi, M.; Hashemi, M.; Badii, F.; Mohammadi, A. Preparation and characterization of a novel bionanocomposite edible film based on pectin and crystalline nanocellulose. Carbohydr. Polym. 2017, 157, 167–175. [Google Scholar] [CrossRef] [PubMed]
- Al-Asmar, A.; Giosafatto, C.V.L.; Sabbah, M.; Sanchez, A.; Santana, R.V.; Mariniello, L. Effect of mesoporous silica nanoparticles on the physicochemical properties of pectin packaging material for strawberry wrapping. Nanomaterials 2020, 10, 52. [Google Scholar] [CrossRef] [PubMed] [Green Version]
- Sucheta; Chaturvedi, K.; Sharma, N.; Yadav, S.K. Composite edible coatings from commercial pectin, corn flour and beetroot powder minimize post-harvest decay, reduces ripening and improves sensory liking of tomatoes. Int. J. Biol. Macromol. 2019, 133, 284–293. [Google Scholar] [CrossRef]
- Rodsamran, P.; Sothornvit, R. Lime peel pectin integrated with coconut water and lime peel extract as a new bioactive film sachet to retard soybean oil oxidation. Food Hydrocoll. 2019, 97, 105173. [Google Scholar] [CrossRef]
- da Silva, I.S.V.; de Sousa, R.M.F.; de Oliveira, A.; de Oliveira, W.J.; Motta, L.A.C.; Pasquini, D.; Otaguro, H. Polymeric blends of hydrocolloid from chia seeds/apple pectin with potential antioxidant for food packaging applications. Carbohydr. Polym. 2018, 202, 203–210. [Google Scholar] [CrossRef] [PubMed]
- Balik, B.A.; Argin, S.; Lagaron, J.M.; Torres-Giner, S. Preparation and characterization of electrospun pectin-based films and their application in sustainable aroma barrier multilayer packaging. Appl. Sci. 2019, 9, 5136. [Google Scholar] [CrossRef] [Green Version]
- Azeredo, H.M.C.; Waldron, K.W. Crosslinking in polysaccharide and protein films and coatings for food contact-A review. Trends Food Sci. Technol. 2016, 52, 109–122. [Google Scholar] [CrossRef]
- Fraeye, I.; Duvetter, T.; Doungla, E.; Loey, A.V.; Hendrickx, M. Fine-tuning the properties of pectin-calcium gels by control of pectin fine structure, gel composition and environmental conditions. Trends Food Sci. Technol. 2010, 21, 219–228. [Google Scholar] [CrossRef]
- Shankar, S.; Teng, X.; Li, G.; Rhim, J.W. Preparation, characterization, and antimicrobial activity of gelatin/ZnO nanocomposite films. Food Hydrocoll. 2015, 45, 264–271. [Google Scholar] [CrossRef]
- Marcous, A.; Rasouli, S.; Ardestani, F. Low-density polyethylene films loaded by titanium dioxide and zinc oxide nanoparticles as a new active packaging system against Escherichia coli O157:H7 in fresh calf minced meat. Packag. Technol. Sci. 2017, 30, 693–701. [Google Scholar] [CrossRef]
- Espitia, P.J.P.; Soares, N.dF.F.; Coimbra, J.S.dR.; de Andrade, N.J.; Cruz, R.S.; Medeiros, E.A.A. Zinc oxide nanoparticles: Synthesis, antimicrobial activity and food packaging applications. Food Bioprocess Technol. 2012, 5, 1447–1464. [Google Scholar] [CrossRef]
- Garcia, C.V.; Shin, G.H.; Kim, J.T. Metal oxide-based nanocomposites in food packaging: Applications, migration, and regulations. Trends Food Sci. Technol. 2018, 82, 21–31. [Google Scholar] [CrossRef]
- American Society for Testing and Material. Standard Test Method for Tensile Properties of Thin Plastic Sheeting; American Society for Testing and Material: West Conshohocken, PA, USA, 2012. [Google Scholar]
- Hosseini, M.H.; Razavi, S.H.; Mousavi, M.A. Antimicrobial, physical and mechanical properties of chitosan-based films incorporated with thyme, clove and cinnamon essential oils. J. Food Process Preserv. 2009, 33, 727–743. [Google Scholar] [CrossRef]
- Lee, J.Y.; Garcia, C.V.; Shin, G.H.; Kim, J.T. Antibacterial and antioxidant properties of hydroxypropyl methylcellulose-based active composite films incorporating oregano essential oil nanoemulsions. LWT 2019, 106, 164–171. [Google Scholar] [CrossRef]
- Nisar, T.; Wang, Z.C.; Yang, X.; Tian, Y.; Iqbal, M.; Guo, Y. Characterization of citrus pectin films integrated with clove bud essential oil: Physical, thermal, barrier, antioxidant and antibacterial properties. Int. J. Biol. Macromol. 2018, 106, 670–680. [Google Scholar] [CrossRef]
- Japanese Industrial Standard. Antimicrobial Products: Test for Antimicrobial Activity and Efficacy; Japanese Industrial Standard: Tokyo, Japan, 2010. [Google Scholar]
- Braccini, I.; Pérez, S. Molecular basis of Ca2+- induced gelation in alginates and pectins: The egg box model revisited. Biomacromolecules 2001, 2, 1089–1096. [Google Scholar] [CrossRef]
- Pavlath, A.E.; Voisin, A.; Robertson, G.H. Pectin-based biodegradable water insoluble films. Macromol. Symp. 1999, 140, 107–113. [Google Scholar] [CrossRef]
- Seixas, F.L.; Turbiani, F.R.B.; Salomão, P.G.; Souza, R.P.; Gimenes, M.L. Biofilms composed of alginate and pectin: Effect of concentration of crosslinker and plasticizer agents. Chem. Eng. Trans. 2013, 32, 1693–1698. [Google Scholar]
- Garavand, F.; Rouhi, M.; Razavi, S.H.; Cacciotti, I.; Mohammadi, R. Improving the integrity of natural biopolymer films used in food packaging by crosslinking approach: A review. Int. J. Biol. Macromol. 2017, 104, 687–707. [Google Scholar] [CrossRef]
- Guo, X.; Duan, H.; Wang, C.; Huang, X. Characteristics of two calcium pectinates prepared from citrus pectin using either calcium chloride or calcium hydroxide. J. Agric. Food Chem. 2014, 62, 6354–6361. [Google Scholar] [CrossRef]
- Nurjaya, S.; Wong, T.W. Effects of microwave on drug release properties of matrices of pectin. Carbohydr. Polym. 2005, 62, 245–257. [Google Scholar] [CrossRef]
- Thibault, J.F.; Rinaudo, M. Chain association of pectic molecules during calcium-induced gelation. Biopolymers 1986, 25, 455–468. [Google Scholar] [CrossRef]
- Ngo, T.M.P.; Dang, T.M.Q.; Tran, T.X.; Rachtanapun, P. Effects of zinc oxide nanoparticles on the properties of pectin/alginate edible films. Int. J. Polym. Sci. 2018, 2018, 5645797. [Google Scholar] [CrossRef] [Green Version]
- Shankar, S.; Tanomrod, N.; Rawdkuen, S.; Rhim, J.W. Preparation of pectin/silver nanoparticles composite films with UV-light barrier and properties. Int. J. Biol. Macromol. 2016, 92, 842–849. [Google Scholar] [CrossRef] [PubMed]
- Kanmani, P.; Rhim, J.W. Properties and characterization of bionanocomposite films prepared with various biopolymers and ZnO nanoparticles. Carbohydr. Polym. 2014, 106, 190–199. [Google Scholar] [CrossRef] [PubMed]
- Ma, X.; Chang, P.R.; Yang, J.; Yu, J. Preparation and properties of glycerol plasticized-pea starch/zinc oxide-starch bionanocomposites. Carbohydr. Polym. 2009, 75, 472–478. [Google Scholar] [CrossRef]
- Assifaoui, A.; Lerbret, A.; Uyen, H.T.D.; Neiers, F.; Chambin, O.; Loupiac, C.; Cousin, F. Structural behaviour differences in low methoxy pectin solutions in the presence of divalent cations (Ca2+ and Zn2+): A process driven by the binding mechanism of the cation with the galacturonate unit. Soft Matter 2015, 11, 551–560. [Google Scholar] [CrossRef] [PubMed]
- Díez-Pascual, A.M.; Díez-Vicente, A.L. ZnO-reinforced poly(3-hydroxybutyrate-co-3-hydroxyvalerate) bionanocomposites with antimicrobial function for food packaging. ACS Appl. Mater. Interfaces 2014, 6, 9822–9834. [Google Scholar] [CrossRef] [PubMed] [Green Version]
- Ahmed, J.; Arfat, Y.A.; Castro-Aguirre, E.; Auras, R. Mechanical, structural and thermal properties of Ag-Cu and ZnO reinforced polylactide nanocomposite films. Int. J. Biol. Macromol. 2016, 86, 885–892. [Google Scholar] [CrossRef]
- Crompton, T.R. Physical Testing of Plastics; Smithers Rapra Technology: Ravenna, OH, USA, 2012; pp. 1–134. [Google Scholar]
- Shankar, S.; Wang, L.F.; Rhim, J.W. Incorporation of zinc oxide nanoparticles improved the mechanical, water vapor barrier, UV-light barrier, and antibacterial properties of PLA-based nanocomposite films. Mat. Sci. Eng. C 2018, 93, 289–298. [Google Scholar] [CrossRef]
- Mishra, R.K.; Sutar, P.B.; Singhal, J.P.; Banthia, A.K. Graft copolymerization of pectin with polyacrylamide. Polym. Plast. Technol. Eng. 2007, 46, 1079–1085. [Google Scholar] [CrossRef]
- Einhorn-Stoll, U.; Kunzek, H.; Dongowski, G. Thermal analysis of chemically and mechanically modified pectins. Food Hydrocoll. 2007, 21, 1101–1112. [Google Scholar] [CrossRef]
- Shi, L.; Gunasekaran, S. Preparation of pectin-ZnO nanocomposite. Nanoscale Res. Lett. 2008, 3, 491–495. [Google Scholar] [CrossRef] [Green Version]
- Li, J.H.; Hong, R.Y.; Li, M.Y.; Li, H.Z.; Zheng, Y.; Ding, J. Effects of ZnO nanoparticles on the mechanical and antibacterial properties of polyurethane coatings. Prog. Org. Coat. 2009, 64, 504–509. [Google Scholar] [CrossRef]
- Tayel, A.A.; El-Tras, W.F.; Moussa, S.; El-Baz, A.F.; Mahrous, H.; Salem, M.F.; Brimer, L. Antibacterial action of zinc oxide nanoparticles against foodborne pathogens. J. Food Saf. 2011, 31, 211–218. [Google Scholar] [CrossRef]
- Zhang, L.; Jiang, Y.; Ding, Y.; Daskalakis, N.; Jeuken, L.; Povey, M.; O’Neill, A.J.; York, D.W. Mechanistic investigation into antibacterial behavior of suspensions of ZnO nanoparticles against E. coli. J. Nanopart. Res. 2010, 12, 1625–1636. [Google Scholar] [CrossRef]

| Sample * | Thickness (µm) | Young’s Modulus (MPa) | Tensile Strength (MPa) | Elongation at Break (%) | Moisture Content (%) | Water Solubility (%) |
|---|---|---|---|---|---|---|
| Control | 85.1 ± 8.1 a | 535.8 ± 54.8 a | 14.3 ± 1.4 a | 8.3 ± 1.1 c | 19.6 ± 1.9 b | 51.3 ± 3.4 b |
| CPF-0.5% | 90.6 ± 10.3 a | 721.8 ± 34.5 b | 18.3 ± 1.4 b | 7.4 ± 0.8 b | 18.3 ± 0.7 b | 47.8 ± 1.0 b |
| CPF-1.0% | 101.5 ± 11.9 b | 857.3 ± 56.5 c | 22.7 ± 1.4 c | 6.1 ± 1.0 a | 14.2 ± 1.2 a | 31.8 ± 2.8 a |
| CPF-2.0% | 93.5 ± 17.9 a | 833.2 ± 121.6 c | 22.0 ± 2.5 c | 5.7 ± 0.7 a | 15.9 ± 0.7 a | 33.4 ± 0.8 a |
| CPF-5.0% | 88.1 ± 6.4 a | 763.3 ± 95.5 b | 21.9 ± 1.4 c | 5.6 ± 1.0 a | 16.0 ± 1.3 a | 32.6 ± 2.6 a |
| Sample * | L | a | b | ∆E |
|---|---|---|---|---|
| CPF | 93.3 ± 0.6 c | −0.23 ± 0.04 c | 6.31 ± 0.67 a | - |
| CPZBF-0.5% | 92.1 ± 0.6 b | −0.29 ± 0.03 b | 8.07 ± 0.54 b | 2.18 ± 0.74 a |
| CPZBF-1.0% | 91.9 ± 0.5 b | −0.36 ± 0.03 a | 8.16 ± 0.54 bc | 2.35 ± 0.65 a |
| CPZBF-1.5% | 91.4 ± 0.2 a | −0.34 ± 0.03 a | 8.52 ± 0.22 c | 2.96 ± 0.25 b |
| Sample * | Thickness (µm) | Young’s Modulus (MPa) | Tensile Strength (MPa) | Elongation at Break (%) | WVP (mm·g/m2 kPa·h) |
|---|---|---|---|---|---|
| CPF | 101.5 ± 11.9 a | 857.3 ± 56.5 ab | 22.7 ± 1.4 a | 6.05 ± 1.01 b | 3.71 ± 0.07 a |
| CPZBF-0.5% | 97.9 ± 13.9 a | 838.8 ± 70.4 a | 24.1 ± 2.2 ab | 5.92 ± 0.89 b | 3.45 ± 0.09 a |
| CPZBF-1.0% | 95.4 ± 15.6 a | 884.0 ± 48.4 b | 24.4 ± 2.1 b | 4.94 ± 0.65 a | 3.56 ± 0.08 ab |
| CPZBF-1.5% | 106.0 ± 13.2 a | 899.4 ± 65.8 b | 24.6 ± 1.8 b | 4.87 ± 0.49 a | 3.63 ± 0.14 ab |
| Sample * | E. coli | S. aureus | ||
|---|---|---|---|---|
| Antibacterial Rate (%) | Antibacterial Activity | Antibacterial Rate (%) | Antibacterial Activity | |
| CPF | 1.9 ± 0.2 a | 0.01 ± 0.01 a | 0.9 ± 0.5 a | 0.00 ± 0.01 a |
| CPZBF-0.5 | 94.1 ± 0.4 b | 1.23 ± 0.03 b | 96.1 ± 0.3 b | 1.41 ± 0.03 b |
| CPZBF-1.0 | 98.2 ± 0.2 c | 1.74 ± 0.05 c | 99.0 ± 0.1 c | 1.98 ± 0.05 c |
| CPZBF-1.5 | 99.1 ± 0.1 c | 2.04 ± 0.04 d | 99.2 ± 0.1 c | 2.11 ± 0.05 d |
Publisher’s Note: MDPI stays neutral with regard to jurisdictional claims in published maps and institutional affiliations. |
© 2021 by the authors. Licensee MDPI, Basel, Switzerland. This article is an open access article distributed under the terms and conditions of the Creative Commons Attribution (CC BY) license (https://creativecommons.org/licenses/by/4.0/).
Share and Cite
Hari, K.D.; Garcia, C.V.; Shin, G.-H.; Kim, J.-T. Improvement of the UV Barrier and Antibacterial Properties of Crosslinked Pectin/Zinc Oxide Bionanocomposite Films. Polymers 2021, 13, 2403. https://doi.org/10.3390/polym13152403
Hari KD, Garcia CV, Shin G-H, Kim J-T. Improvement of the UV Barrier and Antibacterial Properties of Crosslinked Pectin/Zinc Oxide Bionanocomposite Films. Polymers. 2021; 13(15):2403. https://doi.org/10.3390/polym13152403
Chicago/Turabian StyleHari, Karina Dyasti, Coralia V. Garcia, Gye-Hwa Shin, and Jun-Tae Kim. 2021. "Improvement of the UV Barrier and Antibacterial Properties of Crosslinked Pectin/Zinc Oxide Bionanocomposite Films" Polymers 13, no. 15: 2403. https://doi.org/10.3390/polym13152403
APA StyleHari, K. D., Garcia, C. V., Shin, G.-H., & Kim, J.-T. (2021). Improvement of the UV Barrier and Antibacterial Properties of Crosslinked Pectin/Zinc Oxide Bionanocomposite Films. Polymers, 13(15), 2403. https://doi.org/10.3390/polym13152403

